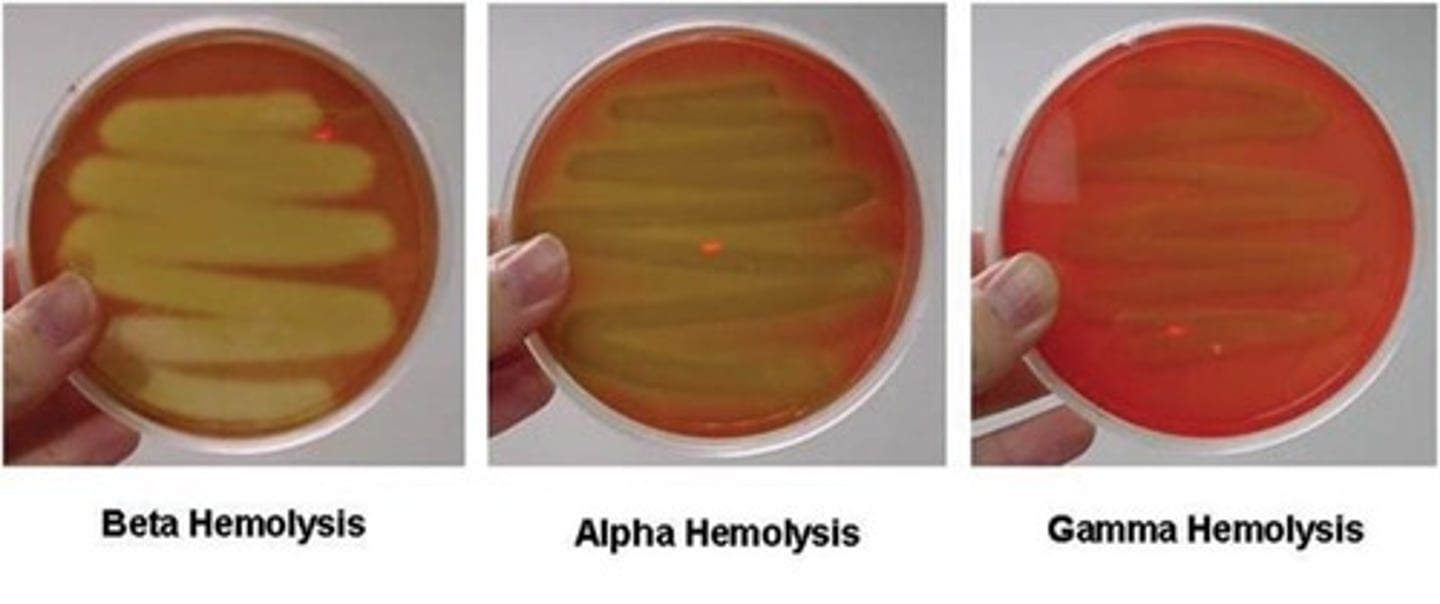
<p>partially breaks down the red blood cells and leaves a greenish color behind. The greenish color is caused by the presence of biliverdin, which is a by-product of the breakdown of hemoglobin.</p>
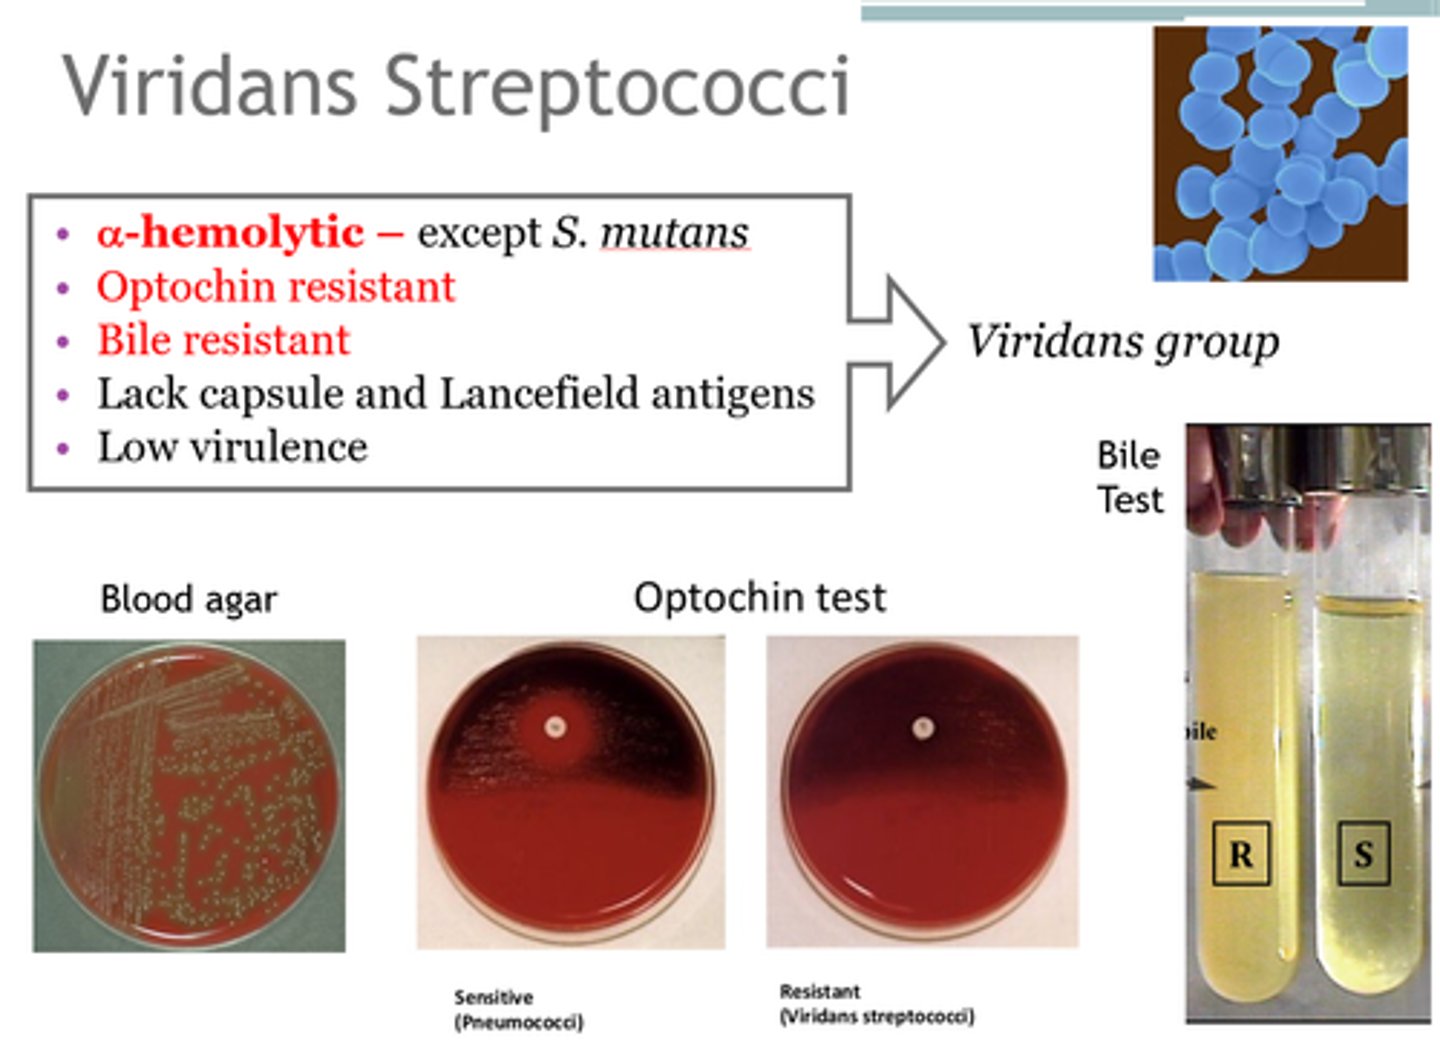
<p>-<strong>Common trait:</strong> α hemolytic, turning blood agar green-ish</p><p>-colonize nasopharynx, oropharynx, or GI tract</p><p><strong>-Medically relevant: <em>S. mutans</em>, </strong><em>S. immitis</em>, <em>S. anginosus</em></p>
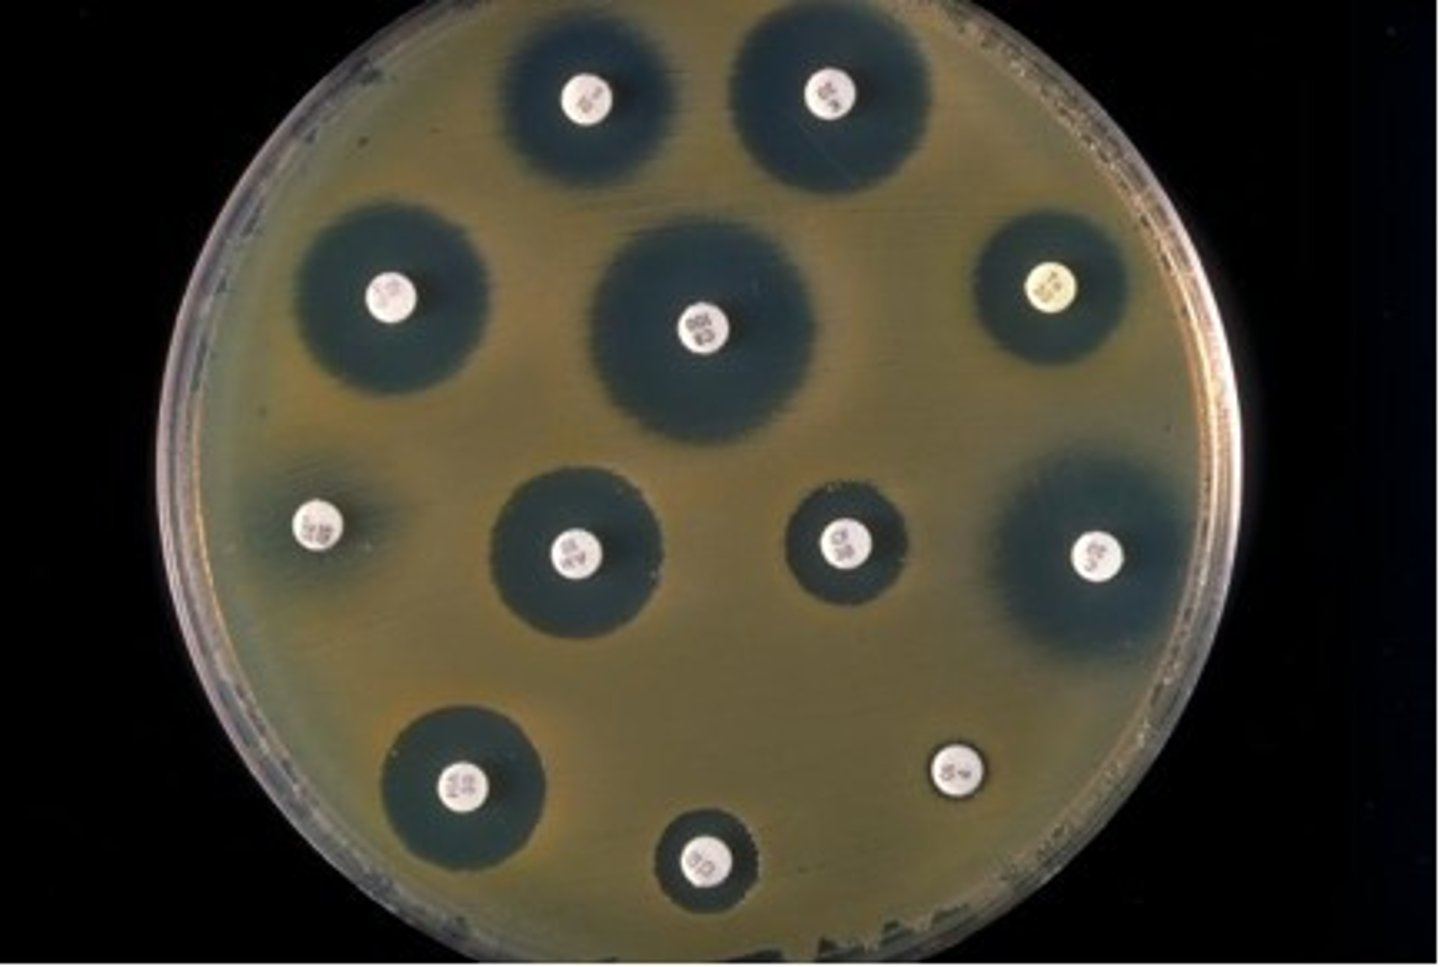
<p>A laboratory test to determine the ability of antibiotics to inhibit bacterial growth.<br>-Kirby Bauer</p>

1/107
Looks like no tags are added yet.
Name | Mastery | Learn | Test | Matching | Spaced | Call with Kai |
|---|
No study sessions yet.
Lysozyme cleaves
peptidoglycan
structural elements of gram-positive bacteria
-Thick peptidoglycan layer
-teichoic and lipoteichoic acids (for stabilization)
gram-positive bacteria lack:
-Lipopolysaccharide
-Outer membrane
-Periplasmic space
beta hemolysis
breaks down the red blood cells and hemoglobin completely leaving a clear zone around the bacterial growth.

alpha hemolysis
partially breaks down the red blood cells and leaves a greenish color behind. The greenish color is caused by the presence of biliverdin, which is a by-product of the breakdown of hemoglobin.
gamma hemolysis
is when a bacteria does not produce hemolysins and does not break down the blood cells, no clearing will occur.

Staphylococcus spp.
-Gram-positive cocci
-Grow in irregular clusters (grape clusters)
-Catalase-positive
clinically important
Staphylococcus spp.
Staphylococcus aureus
S. epidermidis
S. saprophyticus
Staphylococcus Genus
-Gram-positive, coccus, tends to occur in “grape-like” clusters
-Coagulase testing to differentiate staphylococci
-Coagulase-positive = S. aureus (virulence)
-Coagulase-negative staphylococci (CoNS)
-Also, S. aureus can ferment mannitol, but CoNS cannot
shared virulence factors in Staphylococcus spp.
attachment factors, biofilm formation, toxins, enzymes
S. aureus-Specific Virulence Factors
coagulase (clotting), protein A (binds Fc portion of IgG), toxins, drug resistance.
-For drug resistance: mecA gene encoding low-affinity penicillin-binding protein (PBP2); vancomycin resistance is emerging (VRSA)
S. aureus alpha, beta, and gamma toxins
Lyse PMNs and macs to disseminate bacteria and immune evasion
S. aureus toxic shock syndrome
A super-antigen, so induces cytokine storm that has multiple systemic effects
S. aureus - Staphylococcal exfoliative toxins (ETA, ETB)
Cleave desmoglein, separating dermal layers
S. aureus is most ________
virulent (coagulase-positive); think pus!
S. epidermidis is associated with ?
opportunistic infections associated with indwelling devices (catheters, prosthetics, etc
S. saprophyticus is an agent of ______
UTI
Transmission of coagulase-positive of Staphylococcus spp.
-Autoinfection (carrier)
-Direct contact (person with lesion) (10-30% people are carriers!)
-Contaminated food (person with lesion)
-Fomite (Survive long periods of drying)
Transmission of coagulase-negative of Staphylococcus spp.
Autoinfection (infections associated with implanted catheters and prosthetic devices; UTI)
Staphylococcus aureus leukocidins
Two-component toxins which lyse WBC by forming pore
Staphylococcus aureus: Hyaluronidase / Staphylokinase
dissolves extracellular matrix (ECM) and clots!
Staphylococcus aureus: Enzymes for drug resistance
-Penicillinases (also called beta lactamase!)
-mecA gene encoding low-affinity penicillin-binding protein (PBP2); vancomycin resistance is emerging (VRSA)
S. aureus-associated diseases
1. Purulent or inflammatory diseases – direct infection of affected tissue
2. Toxic disease (toxin mediated!) – no infection or infection at site distant to clinical manifestation
3. food poisoning
4. Staphylococcal scalded skin syndrome
5. toxic shock syndrome
Staphylococcal Food Poisoning
Food borne illness. Intoxication (enterotoxin) versus infection. Heat stable toxin. Antibiotic not useful.
Bacteremia and Endocarditis
inflammation of heart chambers.

Cutaneous infections
pus; Furuncle (Boils) & Carbuncle

Impetigo
Superficial infection with production of exfoliative toxins produce large blisters in superficial skin
-associated with S. aureus

Wound infections after surgical procedure S. aureus
Most common skin and soft tissue infections at emergency rooms.
Staphylococcal Scalded Skin Syndrome (SSSS)
-Production of exfoliative toxins that cause erythema (redness of skin) and epidermal desquamation at remote sites from staphylococcal infection
-Most common in neonates and children <5yr
-no scar since only epidermis

Toxic Shock Syndrome
-A systemic disease; caused by TSST-1 (super antigen)
-High fever, vomiting, diarrhea, sore throat and myalgia
-48h can progress to shock with evidence of renal and hepatic damage
-associated with super absorbent tampons

Pneumonia and Empyema (pockets of pus)
-Necrotizing pneumonia
-liquefaction and cavitation of lung tissue
-(Staphylococcus aureus strains that produce Panton-Valentine leukocidin)

Osteomyelitis and Septic Arthritis
Most common cause of osteomyelitis (bone infection!)
Culture and perform sensitivity testing for Staphylococcus
-pus/surface swab, blood, sputum
-grows on blood agar, inoculation onto Mannitol Salt agar (MSA)
-MSA contains 7.5% NaCl which inhibits growth of other normal flora
-Catalase + differentiates from Streptococcus (catalase -)
-Coagulase + differentiates more virulent S. aureus from other species
-Microdilution / Disk Diffusion susceptibility tests should be done

Methicillin-resistant Staphylococcus aureus (MRSA)
At risk: spread in the community by contact with infected people or things that are carrying the bacteria.
-Symptoms: Bump or infected area that is red, swollen, painful, warm to the touch, full of pus or other drainage, accompanied by a fever

MRSA drug is resistance to ?
-to penicillin ring (Beta-lactam) antibiotics
-Resistance is plasmid mediated
-Many strains are even resistant to semisynthetic penicillins (e.g., methicillin)
-Treat with Vancomycin "last resort drug"
Mechanism of MRSA resistance
S. aureus acquired a plasmid encoding the mecA gene
The mecA gene encodes PBP2a protein, a penicillin-binding protein (PBP)
that has a very low affinity for β-lactams
-does not inhibit peptidoglycan synthesis
Staphylococcus epidermidis
-Less virulent than S. aureus due to fewer virulence factors
-opportunistic
Staphylococcus epidermidis most associated diseases
-Post-surgical complication of prosthetic device (e.g. joint implants, heart valves)
-Complication of indwelling device (e.g. IV catheters)
Staphylococcus saprophyticus biochemical profile
-Catalase positive
-Coagulase negative
-Urease positive
-Ferments mannitol
-Novobiocin resistant
Streptococcus spp.
-Gram-positive cocci
-facultative anaerobe
-grow in chains
-catalase-negative

Streptococcus spp. clinically important species
-Streptococcus pyogenes (group A)
-S. pneumoniae (negative)
-S. agalactiae (group B)
Streptococcus pyogenes (pyo = pus!)
-Group A streptococcus or GAS
-M protein: major protein in cell wall of virulent strains. Basis for rheumatic fever.
Streptococcus pyogenes types of diseases
-Localized suppurative (PUS!) disease - pharyngitis (strep throat), skin infection
-Toxin-mediated disease - scarlet fever, toxic shock
-Nonsuppurative (non-PUS!) immune-mediated disease - rheumatic fever (molecular mimicry), acute glomerulonephritis
Streptococcus pyogenes diagnosis
-Antigen detection (rapid strep test - Ab against cell wall carbohydrate)
-Gram stain, culture and biochemical profile (β-hemolytic, bacitracin-sensitive, PYR-positive
Streptococcus pyogenes treatment
penicillin, cephalosporins, ampicillin/amoxicillin, vancomycin (if severe/invasive, add clindamycin for toxin suppression)
S. pyogenes Virulence factors
-Capsule, M protein, C5a peptidase inhibits complement!
-Lipoteichoic acid and F protein – bind fibronectin for adhesion to host cells
-M and F proteins – mediate invasion of mucosal epithelium
S. pyogenes toxins
Streptococcal pyrogenic exotoxins, Streptolysin S and O, Streptokinase A and B
S. pyogenes avoids phagocytosis
-Capsule (contains hyaluronic acid)
-M protein (prevent phagocytosis and degrades complement)
-C5a peptidase
S. pyogenes avoids adherence
M protein, F protein, Lipoteichoic acid (binds fibronectin on epithelium)
S. pyogenes (GAS) Disease: Pharyngitis
-S. pyogenes is major cause of pharyngitis
-Intense pharyngeal redness/edema, tonsillar exudate, and cervical lymphadenopathy

S. pyogenes (GAS) Disease: Scarlet Fever
-Disseminated rash (SCARLET!)
-Tongue initially with yellow-white coating, which shed and becomes raw (strawberry tongue)

S. pyogenes (GAS) Disease: Pyoderma (Impetigo)
-Organism introduced into subcutaneous tissue (insect bite, scratch)
-Vesicle, pustule, rupture, crusts over

S. pyogenes (GAS) Disease: Erysipelas, cellulitis and toxic shock syndrome (TSS)
Erysipelas (red skin); painful cellulitis involving blockage ofdermal lymphatics, therefore, lesions have sharp raised border

S. pyogenes (GAS) Disease: Necrotizing fasciitis
-Also called Streptococcal gangrene
-Extensive destruction of muscles
-"flesh eating bacteria"

S. pyogenes (GAS) Disease: Rheumatic Fever
-After untreated Group A streptococcal pharyngitis involving heart, joints, brain, or skin
-Immune response to antistreptococcal group A carbohydrate
-Autoantibody against cardiac myosin peptides stimulated by M protein and superantigens associated with antibody and T cell responses forming antigen-antibody complexes
S. pyogenes (GAS) Diagnosis
-Gram positive cocci
-Catalase-negative (as with all Streps)
-b-hemolytic
-Bacitracin sensitive
-PYR-positive (produces L-pyrrolidone arylamidase)

Streptococcus agalactiae (GBS)
-Referred to as GBS (Group B streptococcus)
-Colonization predisposes newborns to respiratory distress and septicemiathat may progress to meningitis

Streptococcus agalactiae early onset
Birth – 7 days (Early onset): may lead to respiratory distress with high mortality, infection occurs during birth, types Ia, III, and V
Streptococcus agalactiae late onset
7 days – 4 months (Late onset): Meningitis which commonly leads to permanent neurologic damage and has a fatality rate of 15% to 20%, infection occurs post-partum.
treatment for Streptococcus agalactiae
-reduced or prevented by intrapartum antibiotics (35-38 wks of gestation)
-Treatment: penicillin, ampicillin, 1st & 2nd gen cephalosporins, vancomycin
S. agalactiae Virulence Factors
-Polysaccharide capsule: anti-phagocytic
-Lipoteichoic acid and hyaluronan: attachment, bind fibronectin and CD44, respectively
-Enzymes: C5a peptidase, beta-hemolysin, superoxide dismutase, hyluronate lyase
Streptococcus agalactiae (GBS) Diagnostics
-Gram-positive cocci in chains
-Catalase-negative
-Bacitracin resistant
-Polysaccharide capsule inhibits phagocytosis
-CAMP-positive
-Hippurate hydrolysis-positive

Group C streptococci
-evasion of phagocytosis
-production of hemolysins and other degradative enzymes
-S. anginosus disease: major cause of brain abscess & dental plaque
-S. dysgalactiae disease: pharyngitis
-can be alpha or beta hemolytic
Viridans Streptococci
-Common trait: α hemolytic, turning blood agar green-ish
-colonize nasopharynx, oropharynx, or GI tract
-Medically relevant: S. mutans, S. immitis, S. anginosus
Viridans Streptococci Virulence
-Oral viridans strep: polysaccharide capsule, strong biofilm formation, dextran production (an adhesion that binds fibrin)

Streptococcus pneumoniae (Group Negative)
-Gram-positive
-Diplococci (lancet shaped)
-α-Hemolytic (partial, green)
-Encapsulated
-Quellung reaction positive (capsule swelling with specific antibodies used for typing)
-Optochin (drug!) and bile sensitive

Streptococcus pneumoniae disease frequency and transmission
-Disease frequency: pneumonia > otitis media > meningitis
-MOPS: Meningitis (adult), Otitis media, Pneumonia, and Sinusitis (children)
-Transmission: aerosolized droplets from infected person that are inhaled into the lower airways of susceptible individual
Streptococcus pneumoniae diagnosis
Gram stain of sputum sample; detection of capsule polysaccharide (antigenic) = Quellung reaction; culture and biochemical
-rusty colored sputum
S. pneumoniae Virulence Factors
-Asymptomatic colonization of oropharynx (adhesion to mucus epithelium)
-spread to lower RT (Secretory IgA protease breaks down mucus immunity, Neuraminidase)
-anti-phagocytic mechanisms (capsule and Pneumolysin)
Streptococcus pneumoniae epidemiology
-S. pneumonia is the leading cause of pneumonia, especially in adults
-Infections most common in young (<2y) and old (>60y)
Pneumococcal pneumonia
-Streptococcus pneumoniae
-Shaking chills, high fever, cough, sputum production (tinged with blood), chest pain (5-10d duration)
-Lobar pneumonia w/ air-space consolidation (physical exam & radiagraphically)

Pneumococcal Meningitis
-Streptococcus pneumoniae
-One of the 3 leading causes of bacterial meningitis
-Meningitis may develop solely or follow pneumonia or otitis media (ear infection)
-Headache, stiff neck, fever, photophobia, irritability

S. pneumoniae culture and treatment/prevention
-Culture: Susceptibility to Optochin; rusty sputum; CSF
-Treatment: Pneumococcal Polysaccharide Vaccine, Pneumococcal Conjugate Vaccine (diphtheria toxin)
antibiotic sensitivity test
A laboratory test to determine the ability of antibiotics to inhibit bacterial growth.
-Kirby Bauer
gram positive cocci, catalase positive
Staphylococcus
gram positive cocci, catalase negative
Streptococcus
Gram positive rods
Listeria
Clostridium
toxic shock syndrome toxin
S. Aureus
-super anntigen so induces cytokine storm that has multiple sytsemic effects
staphylococcal exfoliative toxins (ETA, ETB)
toxin of S. aureus
-cleaves desmoglein, separating dermal layers
Staph Scalded Skin Syndrome
agent of UTI
S. saprphyticus
agent oof opportunistic infections associated with indwelling devices
S. epidermidis
exotoxins associated with S. aureus
-enterotoxins- resistant to gut enzymes causing food poisoning
-toxic shock toxin
-exfoliative toxin
How do superantigens work?
-enterotoxin binds MHC II and elicits cytokine bolus and hyperactive CD4 T cell and pro-inflammatory cytokine response

Invasins
-virulence factors of S. aureus and many other bacteria
-ex: coagulase, hylauronidase
common disease presentations of S. aureus
-purulent or inflammatory diseases
-toxic diseases
-food poisoning
-SSSS
-toxic shock
furuncle
boil associated with S. aureus

Staph agar
-yellow=staph aureus
-pink= staph epidermidis
-red: microcooccus luteus

how do we stain staph?
-mannitol salt agar
-MSA contains 7.5% NaCl which inhibits growth of other normal flora
Staph epidermidis is associated with
nosocomial infections!!!
-complication of prosthetic or indwelling devide
important strep species
strep pyogenens
S. pneumo
S. agalactiae
a-hemolytic strep
S. pneumoniae, viridans
-green! partial hemolysis

B-hemolytic streptococci
S. pyogenes and S. agalactiae
-clear, complete hemolysis
Y-hemolytic streptococci:
Enterococcus (GDS)
disease associations of strep pyogenes
-pharyngitis, pyoderma (impetigo), bacteremia, necrotizing fascitis, rheumatic fever
what is the first presentation you think of with S. pyogenes?
pharyngitis!
Presentation of scarlet fever
-disseminated rash
-strawberry tongue
-caused by strep pyogene

pyoderma
Impetigo
S. pyogenes
Eryspelas
-associated with TSS from strep pyogenes
-lesions have sharp raised border

describe the pathogenesis of S. pyogenes
-autoantibody agaisnnt cardiac myosin peptides stimulated by M protein and super antigens associated with Ab and T cell responses forming Ag-Ab complexes
diagnostic hints of S. pyogenes
-gram positive
-catalase neg (as with all streps)
-B hemolytic
-bacitracin sensitive
-PYR positive